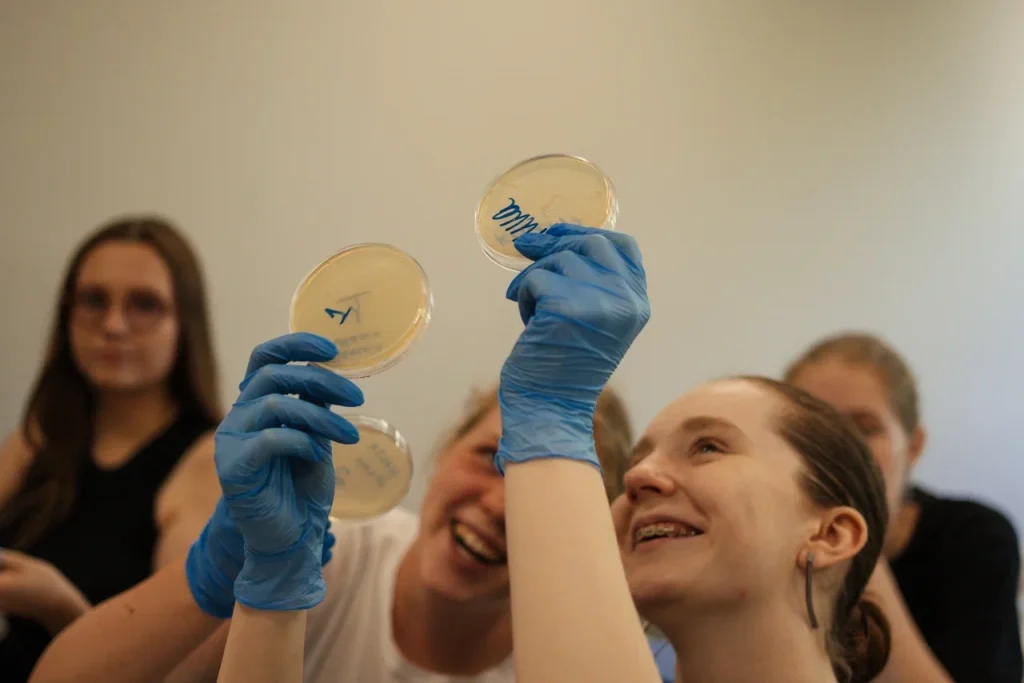

Примите участие в открытом вебинаре по неорганической химии
19 октября в 16:00 приглашаем на вебинар, посвящённый расчётным методам решения задач в олимпиадной неорганической химии. Трансляцию проведёт заведующий кафедрой химии АПО и ОРТШ ЦПМ, член жюри заключительного этапа ВсОШ по химии и научный руководитель химического направления Интерната школы ЦПМ Никита Крысанов. Вебинар проводит ЦПМ совместно с Ассоциацией победителей олимпиад.
На нём мы:
- рассмотрим основные расчётные методы в неорганических задачах;
- научимся решать недоопределённые системы уравнений и грамотно проводить перебор;
- отработаем полученные знания на практике путём решения олимпиадных задач.
Всем зарегистрированным участникам мы отправим не только записи занятий, но и полезные авторские материалы, которые пригодятся при подготовке к химическим олимпиадам!